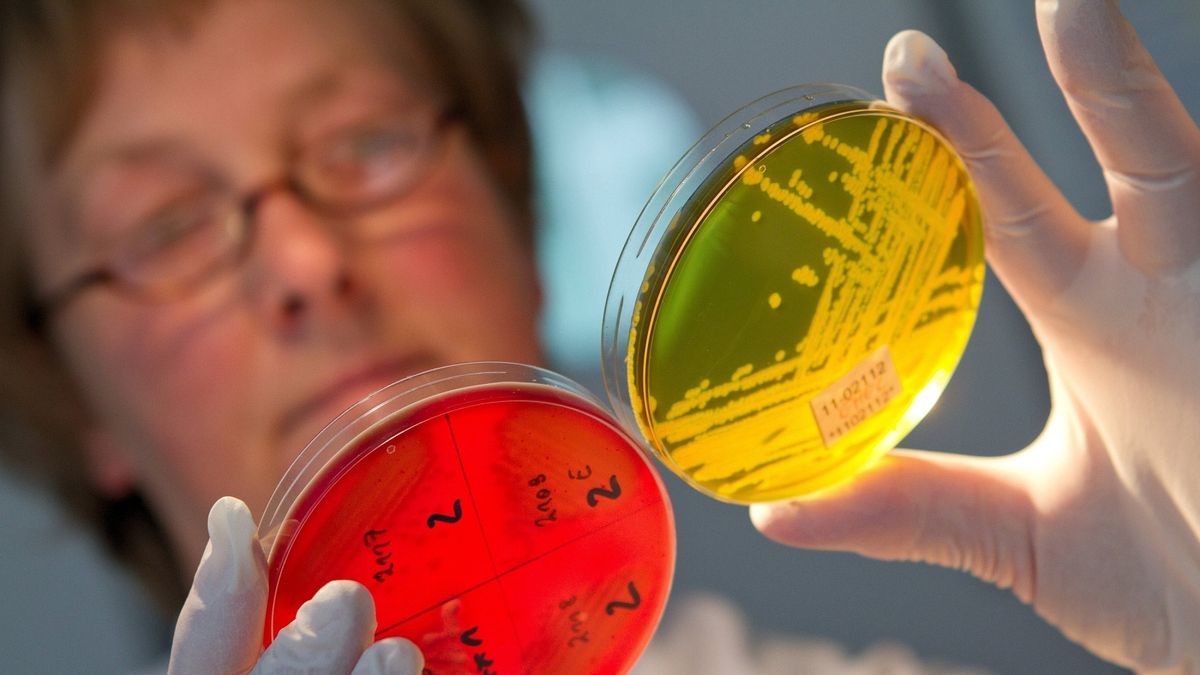
Eine Laborantin des Robert-Koch-Institutes vergleicht EHEC-Kolonien auf Nährboden Eine Laborantin des Robert-Koch-Institutes vergleicht EHEC-Kolonien auf Nährboden

Hamburg. Frunet hatte die Hansestadt verklagt. Nun ist am Landgericht ein Grundsatzurteil zu Gunsten des spanischen Produzenten gefallen.
HA/dpa
Hamburg. Frunet hatte die Hansestadt verklagt. Nun ist am Landgericht ein Grundsatzurteil zu Gunsten des spanischen Produzenten gefallen.
HA/dpa
Kennen Sie schon unsere Plus-Inhalte?
Kennen Sie schon unsere Plus-Inhalte?
Kennen Sie schon unsere PLUS-Inhalte? Jetzt Abendblatt testen